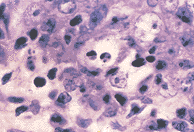

鼻咽癌组织中bcl-2、bax和p53的表达及其与瘤细胞凋亡的关系
作者:李智 宗永生
单位:李智 宗永生(中山医科大学病理教研室,广州 510089)
关键词:鼻咽肿瘤;基因;bcl-2;基因;bax;基因;p53;凋亡
临床与实验病理学杂志990212摘要 目的:了解鼻咽癌组织中瘤细胞bcl-2、bax和p53的表达及其与瘤细胞凋亡指数(apoptosis index, AI)的关系。方法:对38例未经治疗的鼻咽癌组织,应用免疫组化LSAB法检测瘤细胞bcl-2、bax和p53的表达;末端标记细胞死亡检测法(TUNEL)计算癌细胞的凋亡指数。结果:(1)37例(97.4%)中有90%左右的瘤细胞呈bcl-2过表达;(2)38例(100%)中有70%左右的瘤细胞过表达bax;(3)29例(76.3%)呈p53过表达;(4)38例活检组织的平均AI为26.02±26.42/HPF;(5)AI与bcl-2、bax和p53的表达无相关性。结论:(1)本组大多数鼻咽癌组织的绝大部分瘤细胞均呈bcl-2和bax高表达;(2)由于bcl-2和bax的表达已在高水平达到相对平衡,因此在大多数人体鼻咽癌中它们可能并不起到介导瘤细胞凋亡的主导作用;(3)鼻咽癌组织中过表达的p53蛋白可能已失去了调节bcl-2和bax的表达进而影响细胞凋亡的功能。
, 百拇医药
中国图书分类号 R739.6; R392.31 文献标识码 A 文章编号 1001-7399(1999)02-0127-03
Relationship between expression of bcl-2, bax and p53 and apoptosis of neoplastic cells in nasopharyngeal carcinoma
Li Zhi Zong Yongsheng
(Dept of Pathol, Sun Yat-sen University of Medical Sciences, Guangzhou 510089)
ABSTRACT Purpose To detect the expression rates of bcl-2, bax, p53 and correlate them with apoptosis index (AI) of neoplastic cells in nasopharyngeal carcinoma (NPC). Methods Thirty-eight NPC biopsy samples from untreated NPC patients were collected. LSAB immunohistochemical method was adopted to detect the bcl-2, bax and p53 expression. TUNEL (TdT-mediated dUTP nick end labeling) method was used for evaluating the AI. Results (1)About 90% of neoplastic cells expressed bcl-2 in 37 cases (97.4%). (2)About 70% of neoplastic cells expressed bax in all of the 38 NPCs (100%). (3) 29 NPCs (76.3%) underwent p53 overexpression. (4)The mean AI of 38 NPCs was 26.02±26.42 per high-power field. (5)There were no correlations found between AI and the expression rates of bcl-2, bax and p53, respectively. Conclusion (1)Most of the neoplastic cells express bcl-2 and bax simultaneously in vast majority of NPCs. (2)Bcl-2/bax expression in great majority of human NPCs seems not the crucial mediator that takes part in neoplastic cell apoptosis because bcl-2 and bax are overexpressed and balanced at a higher level. (3) The overexpressed p53 in NPCs has possibily lost its function of regulating bcl-2/bax expression and thus influencing cell apoptosis.
, http://www.100md.com
KEY WORDS nasopharyngeal neoplasms; genes, bcl-2; genes, bax; genes, p53; apoptosis
肿瘤细胞凋亡的失控与肿瘤组织的生长关系密切。研究鼻咽癌细胞的凋亡对于了解鼻咽癌的发展有重要的意义。bcl-2和bax是一对调控细胞凋亡的重要基因。关于bcl-2和bax在其它肿瘤中的表达已屡见报道〔1~5〕,但在鼻咽癌组织中却仅见有bcl-2表达的检测〔6~8〕,尚未见bax,特别是bcl-2/bax表达与瘤细胞凋亡相互关系的报道。我们同时检测38例鼻咽癌组织中bcl-2和bax的表达,并将其与瘤细胞的凋亡相联系,探讨bcl-2/bax在鼻咽癌细胞凋亡中的作用。与此同时,我们还研究了bcl-2/bax的上游调控基因p53在鼻咽癌组织中的表达及其与bcl-2和bax表达的关系。上述研究有助于了解bcl-2/bax对鼻咽癌瘤细胞凋亡的影响,为进一步探索鼻咽癌细胞凋亡的机制提供有益的线索。
, http://www.100md.com
1 材料和方法
1.1 材料 38例未经治疗的鼻咽癌活检组织取自中山医科大学所属病理科。标本经10%中性福尔马林液固定,石蜡包埋、切片。
1.2 免疫组化染色 采用Dako公司LSAB(labeled streptavidin biotin)免疫组化试剂盒(Dako K0618)。检测鼻咽癌组织中bcl-2、bax和p53表达的一抗为Dako(bcl-2,p53)和Santa Cruz(bax)公司产品。一抗的工作浓度分别为bcl-2 1∶80,bax 1∶100,p53 1∶100。加一抗前,组织在柠檬酸缓冲液(pH6.0)中经微波预处理10 min。DAB显色,1%甲基绿复染。bcl-2和bax的阳性信号位于胞浆,p53的阳性信号位于细胞核。光镜下观察抗原在癌组织中的表达,以阳性瘤细胞在所有瘤细胞中占有的百分数作为量化指标。
1.3 原位细胞凋亡检测 采用Boehringer Mannheim公司末端标记试剂盒(TdT-mediated dUTP nick end labeling kit, TUNEL)检测鼻咽癌组织中的原位细胞凋亡。BCIP/NBT显色,1%甲基绿复染,阳性信号呈紫蓝色。以细胞凋亡指数(AI),即平均每个HPF(10×40)内的细胞凋亡数,作为鼻咽癌组织中细胞凋亡的量化指标。至少观察10个HPF。
, 百拇医药
2 结果
38例中男性26例,女性12例,平均年龄46.89岁。38例中24例已有颈淋巴结转移。在HE染色片中,凋亡细胞和凋亡小体单个或小灶性地分布在癌巢中或被邻近的细胞所吞噬(图1)。在TUNEL染色片中,紫蓝色的阳性信号多数呈深染的固缩小体,也可仅见于细胞核内(图2)。这些凋亡细胞和凋亡小体在组织中分布极不均匀,且各病例之间的差异也很大。38例鼻咽癌组织的平均凋亡指数(AI)为26.02±26.42/HPF。经统计学分析,AI与患者的年龄、性别和有无淋巴结转移无相关性。
图1 鼻咽未分化癌,可见位于细胞间和细胞内的凋亡小体。HE×200
图2 鼻咽未分化癌,呈TUNEL阳性信号的凋亡细胞散布在癌巢中。TUNEL×200
, 百拇医药
38例鼻咽癌组织中,bcl-2的阳性表达率为97.4%(37/38)(图3)。在37例阳性病例中,bcl-2阳性瘤细胞百分数的中位数为90%,即90%左右的瘤细胞均过表达bcl-2。38例鼻咽癌组织中bax的阳性表达率为100%(38/38)(图4)。Bax阳性瘤细胞百分数的中位数70%,即70%左右的瘤细胞均过表达bax。在38例鼻咽癌组织bcl-2和bax阳性瘤细胞百分数的散点分布图中,可见绝大多数散点均集中位于高表达区内(图5)。在38例鼻咽癌组织中,37例(97.4%)均有不同数量(5%~100%)的p53阳性瘤细胞(图6)。超过20% p53阳性瘤细胞的鼻咽癌组织有29例。如果以此为p53过表达的标准,则p53的过表达率为76.3%(29/38)。
图3 鼻咽未分化癌,大多数癌细胞呈bcl-2胞浆、胞膜阳性。LSAB×50
, http://www.100md.com
图4 鼻咽未分化癌,部分癌细胞呈bax胞浆阳性。LSAB×100
图5 38例鼻咽癌bcl-2、bax阳性瘤细胞百分数散点分布图
▲指各例表达bcl-2和bax的百分数;●指表达bcl-2和bax的中位百分数
图6 鼻咽未分化癌,大多数癌细胞核呈p53阳性。LSAB×50
将38例鼻咽癌组织中的bcl-2、bax阳性瘤细胞百分数分别与AI作Spearman等级相关检验,rs分别为0.137和0.239,P值分别为>0.2和>0.1,显示无相关性。又将38例鼻咽癌组织中的bcl-2、bax阳性瘤细胞百分数分别与p53阳性细胞百分数作Spearman等级相关检验,rs分别为0.154和0.238,P值分别为>0.2和>0.1,也显示无相关性。p53阳性瘤细胞百分数与AI无等级相关,rs=0.213,P>0.01。
, 百拇医药
3 讨论
Bcl-2和bax是细胞凋亡相关基因bcl-2家族中的重要成员〔9〕。在细胞中bcl-2蛋白和bax蛋白以二聚体的形式存在。如bcl-2和bax的表达量相互平衡,形成的bcl-2/bax异二聚体占优势,则细胞的存活期正常;如bcl-2过表达而bax的表达不相应增多,使形成的bcl-2/bcl-2同二聚体占优势,则细胞存活期延长;如bax过表达而bcl-2的表达不相应增多,使形成的bax/bax同二聚体占优势,则诱发细胞凋亡〔10〕。因此bcl-2/bax表达量的比值,对细胞存活与凋亡起着十分重要的作用。bcl-2和bax是一对细胞凋亡的正负调节基因。bcl-2和bax基因的激活及其蛋白的过表达可见于多种肿瘤组织〔1~5〕。在鼻咽癌组织中,bcl-2的表达率文献报道为25%(11/44)~82.6%(38/46)之间〔6~8〕。我们的结果显示,除一例明确阴性外,bcl-2的表达率竟高达97.4%(37/38),而且90%左右(40%~100%,中位数90%)的瘤细胞呈bcl-2阳性,说明bcl-2的过表达是鼻咽癌细胞的一个突出的生物学特性。Bax在鼻咽癌组织中的表达至今尚未见有报道。本文所研究的38例鼻咽癌组织均有bax的表达,而且70%左右(50~95%,中位数70%)的瘤细胞呈bax阳性,说明bax的过表达也是鼻咽癌细胞的一个突出的生物学特性。至于是否有bax阴性的鼻咽癌病例,则需增加例数给予证实。总之本研究结果说明,在本组大多数鼻咽癌组织的大部分瘤细胞中均同时呈bcl-2和bax高表达。bcl-2和bax在一些肿瘤,例如胃癌〔3〕、甲状腺癌〔4〕或卵巢癌〔5〕组织中同时表达文献中也已有报道。
, 百拇医药
既然bcl-2和bax是细胞凋亡相关基因,它们在瘤细胞内的激活和过表达理应与瘤细胞凋亡密切相关。但38例鼻咽癌组织中的凋亡指数却分别与表达bcl-2和bax的瘤细胞百分数并无相关性。我们认为,正是因为绝大多数瘤细胞同时高表达bcl-2和bax,bcl-2/bax异二聚体仍占主导地位,所以单独联系bcl-2和bax的阳性瘤细胞百分数与凋亡指数间的关系时就不能显示其相关性了。由此提示,在大多数人体鼻咽癌组织中,bcl-2和bax之所以不起到介导瘤细胞凋亡的主导作用,是因为bcl-2和bax的表达已在高水平上达到相对平衡的缘故。38例中有个别病例bcl-2和bax的表达量相差较大,因此进一步探讨影响bcl-2和bax不平衡表达的因素,例如bcl-2家族中的其它基因bcl-xl、bcl-xs和bad等就显得有必要。一旦bcl-2和bax在瘤细胞内的表达量不平衡,势必影响瘤细胞的凋亡。我们实验室的结果证实了这一点。在CNE-1和CNE-2鼻咽癌细胞株裸鼠移植瘤组织中,bcl-2阴性,表达bax的瘤细胞数与凋亡指数呈正相关,bax/bax同二聚体确能介导鼻咽癌细胞的凋亡(材料已另文发表)。除了研究介导细胞凋亡的内源性因素bcl-2家族外,研究外源性因素,例如Fas系统、细胞毒性T细胞等介导的鼻咽癌细胞凋亡也十分必要。
, 百拇医药
已知p53是bcl-2和bax的上游调控基因,野生型p53蛋白能够下调bcl-2和上调bax的表达,从而介导细胞的凋亡〔10〕。本组38例鼻咽癌组织中p53蛋白阳性瘤细胞百分数与bcl-2阳性和bax阳性瘤细胞百分数以及凋亡指数间均无相关性。这说明鼻咽癌组织中所检测到的p53已失去了调节bcl-2和bax的表达进而影响细胞凋亡的功能。由于鼻咽癌组织中p53基因只有10%的突变率〔11〕,因此免疫组化所检测到的p53蛋白大部分是非突变型的,是野生型p53蛋白与细胞中其它蛋白(例如mdm2和EB病毒蛋白EBNA-5、ZEBRA等)结合形成的蛋白复合体。本研究说明,在鼻咽癌组织中这种结合的p53蛋白已经失去了调节bcl-2和bax的功能。
基金项目:国家自然科学基金资助课题(No 39730200-Ⅱ)
作者简介:李智,男,28岁,博士研究生
, 百拇医药 宗永生,男,72岁,教授,博士生导师。研究方向:鼻咽癌
参考文献
1 King ED, Matteson J, Jacobs SC et al. Incidence of apoptosis, cell proliferation and bcl-2 expression in transitional cell carcinoma of bladder association with tumor progression. J Urol,1996;155:316
2 Baretten GB, Diebold J, Christoforis G et al. Apoptosis and immunohistochemical bcl-2 expression in colorectal adenomas and carcinomas. Cancer, 1996;77:255
, 百拇医药
3 Koshida Y, Saegusa M, Okayasu I et al. Apoptosis, cell proliferation and expression of bcl-2 and bax in gastric carcinomas immunohistochemical and clinicopathological study. Br J Cancer,1997;75(3):367~373
4 Manetto V, Lorenzini R, Cordon Cardo C et al. Bcl-2 and bax expression in thyroid tumors. An immunohistochemical and western blot analysis. Virchows Arch, 1997;430(2):125~130
5 Marx D, Binder C, Meden H et al. Differential expression of apoptosis associated genes bax and bcl-2 in ovarian. Cancer,1997;17:2233~2240
, 百拇医药
6 Lu QL, Elia G, Lucas S et al. bcl-2 proto-oncogene expression in Epstein-Barr virus associated nasopharyngeal carcinoma. Int J Cancer,1993;53:29
7 郭琳琅,曹长安. EB病毒感染及抗凋亡基因bcl-2与鼻咽癌关系的研究. 实用癌症杂志,1997;12(3):167~168
8 Kouvidou CH, Kanavaros P, Papaioannou D et al. Expression of bcl-2 and p53 protein in nasopharyngeal carcinoma. Absence of correlation with the presence of EBV encoded EBER1-2 transcripts and latent membrane protein. J Clin Pathol,1995;48:17
, http://www.100md.com
9 Nagata S. Apoptosis by death factor. Cell,1997;88:355~365
10 Oltvai ZN, Milliman CL, Korsmeyer SJ. Bcl-2 heterodimerizes in vivo with a conserved homolog Bax, that accelerates programmed cell death. Cell,1993;74(4):609~619
11 Spruck CH, Tsai YC, Huang DP et al. Absence of p53 gene mutations in primary nasopharyngeal carcinomas. Cancer Res,1992;52(17):4787~4790
收稿日期:1998-12-25, http://www.100md.com
单位:李智 宗永生(中山医科大学病理教研室,广州 510089)
关键词:鼻咽肿瘤;基因;bcl-2;基因;bax;基因;p53;凋亡
临床与实验病理学杂志990212摘要 目的:了解鼻咽癌组织中瘤细胞bcl-2、bax和p53的表达及其与瘤细胞凋亡指数(apoptosis index, AI)的关系。方法:对38例未经治疗的鼻咽癌组织,应用免疫组化LSAB法检测瘤细胞bcl-2、bax和p53的表达;末端标记细胞死亡检测法(TUNEL)计算癌细胞的凋亡指数。结果:(1)37例(97.4%)中有90%左右的瘤细胞呈bcl-2过表达;(2)38例(100%)中有70%左右的瘤细胞过表达bax;(3)29例(76.3%)呈p53过表达;(4)38例活检组织的平均AI为26.02±26.42/HPF;(5)AI与bcl-2、bax和p53的表达无相关性。结论:(1)本组大多数鼻咽癌组织的绝大部分瘤细胞均呈bcl-2和bax高表达;(2)由于bcl-2和bax的表达已在高水平达到相对平衡,因此在大多数人体鼻咽癌中它们可能并不起到介导瘤细胞凋亡的主导作用;(3)鼻咽癌组织中过表达的p53蛋白可能已失去了调节bcl-2和bax的表达进而影响细胞凋亡的功能。
, 百拇医药
中国图书分类号 R739.6; R392.31 文献标识码 A 文章编号 1001-7399(1999)02-0127-03
Relationship between expression of bcl-2, bax and p53 and apoptosis of neoplastic cells in nasopharyngeal carcinoma
Li Zhi Zong Yongsheng
(Dept of Pathol, Sun Yat-sen University of Medical Sciences, Guangzhou 510089)
ABSTRACT Purpose To detect the expression rates of bcl-2, bax, p53 and correlate them with apoptosis index (AI) of neoplastic cells in nasopharyngeal carcinoma (NPC). Methods Thirty-eight NPC biopsy samples from untreated NPC patients were collected. LSAB immunohistochemical method was adopted to detect the bcl-2, bax and p53 expression. TUNEL (TdT-mediated dUTP nick end labeling) method was used for evaluating the AI. Results (1)About 90% of neoplastic cells expressed bcl-2 in 37 cases (97.4%). (2)About 70% of neoplastic cells expressed bax in all of the 38 NPCs (100%). (3) 29 NPCs (76.3%) underwent p53 overexpression. (4)The mean AI of 38 NPCs was 26.02±26.42 per high-power field. (5)There were no correlations found between AI and the expression rates of bcl-2, bax and p53, respectively. Conclusion (1)Most of the neoplastic cells express bcl-2 and bax simultaneously in vast majority of NPCs. (2)Bcl-2/bax expression in great majority of human NPCs seems not the crucial mediator that takes part in neoplastic cell apoptosis because bcl-2 and bax are overexpressed and balanced at a higher level. (3) The overexpressed p53 in NPCs has possibily lost its function of regulating bcl-2/bax expression and thus influencing cell apoptosis.
, http://www.100md.com
KEY WORDS nasopharyngeal neoplasms; genes, bcl-2; genes, bax; genes, p53; apoptosis
肿瘤细胞凋亡的失控与肿瘤组织的生长关系密切。研究鼻咽癌细胞的凋亡对于了解鼻咽癌的发展有重要的意义。bcl-2和bax是一对调控细胞凋亡的重要基因。关于bcl-2和bax在其它肿瘤中的表达已屡见报道〔1~5〕,但在鼻咽癌组织中却仅见有bcl-2表达的检测〔6~8〕,尚未见bax,特别是bcl-2/bax表达与瘤细胞凋亡相互关系的报道。我们同时检测38例鼻咽癌组织中bcl-2和bax的表达,并将其与瘤细胞的凋亡相联系,探讨bcl-2/bax在鼻咽癌细胞凋亡中的作用。与此同时,我们还研究了bcl-2/bax的上游调控基因p53在鼻咽癌组织中的表达及其与bcl-2和bax表达的关系。上述研究有助于了解bcl-2/bax对鼻咽癌瘤细胞凋亡的影响,为进一步探索鼻咽癌细胞凋亡的机制提供有益的线索。
, http://www.100md.com
1 材料和方法
1.1 材料 38例未经治疗的鼻咽癌活检组织取自中山医科大学所属病理科。标本经10%中性福尔马林液固定,石蜡包埋、切片。
1.2 免疫组化染色 采用Dako公司LSAB(labeled streptavidin biotin)免疫组化试剂盒(Dako K0618)。检测鼻咽癌组织中bcl-2、bax和p53表达的一抗为Dako(bcl-2,p53)和Santa Cruz(bax)公司产品。一抗的工作浓度分别为bcl-2 1∶80,bax 1∶100,p53 1∶100。加一抗前,组织在柠檬酸缓冲液(pH6.0)中经微波预处理10 min。DAB显色,1%甲基绿复染。bcl-2和bax的阳性信号位于胞浆,p53的阳性信号位于细胞核。光镜下观察抗原在癌组织中的表达,以阳性瘤细胞在所有瘤细胞中占有的百分数作为量化指标。
1.3 原位细胞凋亡检测 采用Boehringer Mannheim公司末端标记试剂盒(TdT-mediated dUTP nick end labeling kit, TUNEL)检测鼻咽癌组织中的原位细胞凋亡。BCIP/NBT显色,1%甲基绿复染,阳性信号呈紫蓝色。以细胞凋亡指数(AI),即平均每个HPF(10×40)内的细胞凋亡数,作为鼻咽癌组织中细胞凋亡的量化指标。至少观察10个HPF。
, 百拇医药
2 结果
38例中男性26例,女性12例,平均年龄46.89岁。38例中24例已有颈淋巴结转移。在HE染色片中,凋亡细胞和凋亡小体单个或小灶性地分布在癌巢中或被邻近的细胞所吞噬(图1)。在TUNEL染色片中,紫蓝色的阳性信号多数呈深染的固缩小体,也可仅见于细胞核内(图2)。这些凋亡细胞和凋亡小体在组织中分布极不均匀,且各病例之间的差异也很大。38例鼻咽癌组织的平均凋亡指数(AI)为26.02±26.42/HPF。经统计学分析,AI与患者的年龄、性别和有无淋巴结转移无相关性。
图1 鼻咽未分化癌,可见位于细胞间和细胞内的凋亡小体。HE×200
图2 鼻咽未分化癌,呈TUNEL阳性信号的凋亡细胞散布在癌巢中。TUNEL×200
, 百拇医药
38例鼻咽癌组织中,bcl-2的阳性表达率为97.4%(37/38)(图3)。在37例阳性病例中,bcl-2阳性瘤细胞百分数的中位数为90%,即90%左右的瘤细胞均过表达bcl-2。38例鼻咽癌组织中bax的阳性表达率为100%(38/38)(图4)。Bax阳性瘤细胞百分数的中位数70%,即70%左右的瘤细胞均过表达bax。在38例鼻咽癌组织bcl-2和bax阳性瘤细胞百分数的散点分布图中,可见绝大多数散点均集中位于高表达区内(图5)。在38例鼻咽癌组织中,37例(97.4%)均有不同数量(5%~100%)的p53阳性瘤细胞(图6)。超过20% p53阳性瘤细胞的鼻咽癌组织有29例。如果以此为p53过表达的标准,则p53的过表达率为76.3%(29/38)。
图3 鼻咽未分化癌,大多数癌细胞呈bcl-2胞浆、胞膜阳性。LSAB×50
, http://www.100md.com
图4 鼻咽未分化癌,部分癌细胞呈bax胞浆阳性。LSAB×100
图5 38例鼻咽癌bcl-2、bax阳性瘤细胞百分数散点分布图
▲指各例表达bcl-2和bax的百分数;●指表达bcl-2和bax的中位百分数
图6 鼻咽未分化癌,大多数癌细胞核呈p53阳性。LSAB×50
将38例鼻咽癌组织中的bcl-2、bax阳性瘤细胞百分数分别与AI作Spearman等级相关检验,rs分别为0.137和0.239,P值分别为>0.2和>0.1,显示无相关性。又将38例鼻咽癌组织中的bcl-2、bax阳性瘤细胞百分数分别与p53阳性细胞百分数作Spearman等级相关检验,rs分别为0.154和0.238,P值分别为>0.2和>0.1,也显示无相关性。p53阳性瘤细胞百分数与AI无等级相关,rs=0.213,P>0.01。
, 百拇医药
3 讨论
Bcl-2和bax是细胞凋亡相关基因bcl-2家族中的重要成员〔9〕。在细胞中bcl-2蛋白和bax蛋白以二聚体的形式存在。如bcl-2和bax的表达量相互平衡,形成的bcl-2/bax异二聚体占优势,则细胞的存活期正常;如bcl-2过表达而bax的表达不相应增多,使形成的bcl-2/bcl-2同二聚体占优势,则细胞存活期延长;如bax过表达而bcl-2的表达不相应增多,使形成的bax/bax同二聚体占优势,则诱发细胞凋亡〔10〕。因此bcl-2/bax表达量的比值,对细胞存活与凋亡起着十分重要的作用。bcl-2和bax是一对细胞凋亡的正负调节基因。bcl-2和bax基因的激活及其蛋白的过表达可见于多种肿瘤组织〔1~5〕。在鼻咽癌组织中,bcl-2的表达率文献报道为25%(11/44)~82.6%(38/46)之间〔6~8〕。我们的结果显示,除一例明确阴性外,bcl-2的表达率竟高达97.4%(37/38),而且90%左右(40%~100%,中位数90%)的瘤细胞呈bcl-2阳性,说明bcl-2的过表达是鼻咽癌细胞的一个突出的生物学特性。Bax在鼻咽癌组织中的表达至今尚未见有报道。本文所研究的38例鼻咽癌组织均有bax的表达,而且70%左右(50~95%,中位数70%)的瘤细胞呈bax阳性,说明bax的过表达也是鼻咽癌细胞的一个突出的生物学特性。至于是否有bax阴性的鼻咽癌病例,则需增加例数给予证实。总之本研究结果说明,在本组大多数鼻咽癌组织的大部分瘤细胞中均同时呈bcl-2和bax高表达。bcl-2和bax在一些肿瘤,例如胃癌〔3〕、甲状腺癌〔4〕或卵巢癌〔5〕组织中同时表达文献中也已有报道。
, 百拇医药
既然bcl-2和bax是细胞凋亡相关基因,它们在瘤细胞内的激活和过表达理应与瘤细胞凋亡密切相关。但38例鼻咽癌组织中的凋亡指数却分别与表达bcl-2和bax的瘤细胞百分数并无相关性。我们认为,正是因为绝大多数瘤细胞同时高表达bcl-2和bax,bcl-2/bax异二聚体仍占主导地位,所以单独联系bcl-2和bax的阳性瘤细胞百分数与凋亡指数间的关系时就不能显示其相关性了。由此提示,在大多数人体鼻咽癌组织中,bcl-2和bax之所以不起到介导瘤细胞凋亡的主导作用,是因为bcl-2和bax的表达已在高水平上达到相对平衡的缘故。38例中有个别病例bcl-2和bax的表达量相差较大,因此进一步探讨影响bcl-2和bax不平衡表达的因素,例如bcl-2家族中的其它基因bcl-xl、bcl-xs和bad等就显得有必要。一旦bcl-2和bax在瘤细胞内的表达量不平衡,势必影响瘤细胞的凋亡。我们实验室的结果证实了这一点。在CNE-1和CNE-2鼻咽癌细胞株裸鼠移植瘤组织中,bcl-2阴性,表达bax的瘤细胞数与凋亡指数呈正相关,bax/bax同二聚体确能介导鼻咽癌细胞的凋亡(材料已另文发表)。除了研究介导细胞凋亡的内源性因素bcl-2家族外,研究外源性因素,例如Fas系统、细胞毒性T细胞等介导的鼻咽癌细胞凋亡也十分必要。
, 百拇医药
已知p53是bcl-2和bax的上游调控基因,野生型p53蛋白能够下调bcl-2和上调bax的表达,从而介导细胞的凋亡〔10〕。本组38例鼻咽癌组织中p53蛋白阳性瘤细胞百分数与bcl-2阳性和bax阳性瘤细胞百分数以及凋亡指数间均无相关性。这说明鼻咽癌组织中所检测到的p53已失去了调节bcl-2和bax的表达进而影响细胞凋亡的功能。由于鼻咽癌组织中p53基因只有10%的突变率〔11〕,因此免疫组化所检测到的p53蛋白大部分是非突变型的,是野生型p53蛋白与细胞中其它蛋白(例如mdm2和EB病毒蛋白EBNA-5、ZEBRA等)结合形成的蛋白复合体。本研究说明,在鼻咽癌组织中这种结合的p53蛋白已经失去了调节bcl-2和bax的功能。
基金项目:国家自然科学基金资助课题(No 39730200-Ⅱ)
作者简介:李智,男,28岁,博士研究生
, 百拇医药 宗永生,男,72岁,教授,博士生导师。研究方向:鼻咽癌
参考文献
1 King ED, Matteson J, Jacobs SC et al. Incidence of apoptosis, cell proliferation and bcl-2 expression in transitional cell carcinoma of bladder association with tumor progression. J Urol,1996;155:316
2 Baretten GB, Diebold J, Christoforis G et al. Apoptosis and immunohistochemical bcl-2 expression in colorectal adenomas and carcinomas. Cancer, 1996;77:255
, 百拇医药
3 Koshida Y, Saegusa M, Okayasu I et al. Apoptosis, cell proliferation and expression of bcl-2 and bax in gastric carcinomas immunohistochemical and clinicopathological study. Br J Cancer,1997;75(3):367~373
4 Manetto V, Lorenzini R, Cordon Cardo C et al. Bcl-2 and bax expression in thyroid tumors. An immunohistochemical and western blot analysis. Virchows Arch, 1997;430(2):125~130
5 Marx D, Binder C, Meden H et al. Differential expression of apoptosis associated genes bax and bcl-2 in ovarian. Cancer,1997;17:2233~2240
, 百拇医药
6 Lu QL, Elia G, Lucas S et al. bcl-2 proto-oncogene expression in Epstein-Barr virus associated nasopharyngeal carcinoma. Int J Cancer,1993;53:29
7 郭琳琅,曹长安. EB病毒感染及抗凋亡基因bcl-2与鼻咽癌关系的研究. 实用癌症杂志,1997;12(3):167~168
8 Kouvidou CH, Kanavaros P, Papaioannou D et al. Expression of bcl-2 and p53 protein in nasopharyngeal carcinoma. Absence of correlation with the presence of EBV encoded EBER1-2 transcripts and latent membrane protein. J Clin Pathol,1995;48:17
, http://www.100md.com
9 Nagata S. Apoptosis by death factor. Cell,1997;88:355~365
10 Oltvai ZN, Milliman CL, Korsmeyer SJ. Bcl-2 heterodimerizes in vivo with a conserved homolog Bax, that accelerates programmed cell death. Cell,1993;74(4):609~619
11 Spruck CH, Tsai YC, Huang DP et al. Absence of p53 gene mutations in primary nasopharyngeal carcinomas. Cancer Res,1992;52(17):4787~4790
收稿日期:1998-12-25, http://www.100md.com